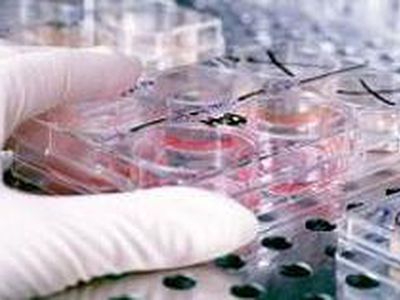
ВОЗ: Лекарства для лечения свиного гриппа уже существуют - Наука и здоровье

О военных учениях Литвы, проходящих с 4 по 22 мая
Учения планируется проводить и в Висагинском самоуправлении

Эта мысль «красной нитью» проходила через весь семинар, состоявшийся 24 апреля в Доме детского творчества

Оправдаются ли подозрения на «свиной грипп» у прибывшего из Мексики гражданина Литвы, пока не ясно


«Гриппозная» паника привела к опустошению аптечных прилавков.

Финский доцент Иохан Бэкман распространяет идею об объединении Эстонии и Финляндии


Впервые в истории НХЛ три российских игрока стали претендентами на награду «Харт Трофи», которая вручается самому ценному игроку регулярного чемпионата ...

Российский теннисист Николай Давыденко проиграл в своем первом матче на турнире серии «Мастерс» в Риме


Итальянский автопроизводитель FIAT обновил кроссовер Sedici

На основании договора о сотрудничестве, на нашем сайте размещается электронная версия новой русскоязычной газеты «Вестник соотечественника».

ВОЗ предупреждает: энергосберегающие электролампы могут быть опасны для здоровья – если разобьются

Схема зон с особыми условиями использования территории Калининградской области с чёрным квадратом

Пейдж занимается благотворительностью более 20 лет

Одним из соперников Швеции на втором групповом этапе будет сборная России

Шестую в своей жизни премию Nebula получила знаменитая писательница-фантаст из США Урсула Ле Гуин, сообщает The Guardian

Бывший полузащитник «Реала» Зинедин Зидан выразил мнение, что в только случае победы мадридцев над «Барселоной» в 34-м туре примеры королевский ...

Джеки Чан анонсировал свой сотый кинопроект

Сейм Литвы в срочном порядке рассмотрел и принял новый порядок компенсаций за «больничные дни»

Лекарства для лечения свиного гриппа уже существуют

Исполнительный директор Microsoft Стив Балмер рассказывает о возможностях Windows 7 (январь, выставка CES 2009)

А.Кубилюс: во второй половине 2010 года Литва приблизится к Маастрихтскому критерию

«Семнадцать мгновений весны» и «В бой идут одни старики» выйдут в цвете

Болгария обратилась к России с просьбой предоставить ей кредит на строительство АЭС «Белене»

Вашингтон настаивает на пересмотре соглашения о выводе американских войск, заключенного в прошлом году с Багдадом

Контейнер, в котором находились образцы вируса свиного гриппа, взорвался в пассажирском поезде в Швейцарии


В январе 2009 года в серии «Матерь святых - шедевры грузинские агиографии», в свет вышла книга «Житие Святого Григола Хандзтели».

Научно-популярный журнал New Scientist сообщает, что ученые разработали новый способ защиты сердца и мозга человека от инфаркта и инсульта